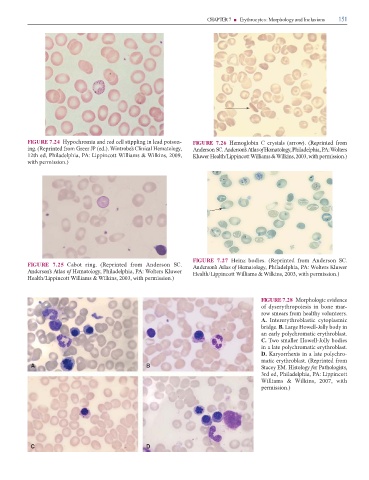

Page 167 - Clinical Hematology_ Theory _ Procedures ( PDFDrive )
P. 167
CHAPTER 7 ■ Erythrocytes: Morphology and Inclusions 151
FIGURE 7.24 H m - FIGURE 7.26 H m C (arrow). (R m
. (R m G JP ( .). Wintrobe’s Clinical Hematology, A SC. Anderson’s Atlas o Hematology, P , PA: W
, P , PA: L W m & W k , , K H /L W m & W k , , m .)
m .)
FIGURE 7.27 H z . (R m A SC.
FIGURE 7.25 C . (R m A SC. Anderson’s Atlas o Hematology, P , PA: W K
Anderson’s Atlas o Hematology, P , PA: W K H /L W m & W k , , m .)
H /L W m & W k , , m .)
FIGURE 7.28 M
m -
m m .
A. I m
. B. L H -J
m .
C. m H -J
m .
D. K x -
m . (R m
S EM. Histology or Pathologists,
, P , PA: L
W m & W k , ,
m .)